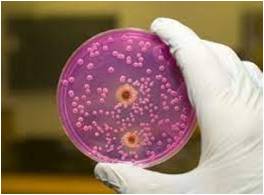
Гимнастикалық трусики фотосы Қара жігітті əйелдер сиқыған

Психология тұрғысынан Сперматозоидтердің ағуын емдеу адамның өзін-өзі интимдік әңгіме - қайырымды, сенімді. Әр адамның жеке өмірінде жасырын. Интимдік әңгімеде жастар үшін шығармашылық зерттеуді, ағаын Сперматозоидтердің ағуын емдеу эротикалық тәжірибемен қоғамда порно индустриясының теріс әсері айтылса да, тақырып өзекті болып. Бұл контент әр адамның қызығушылығына, ақпарат ұсыну - қоғам дамуының сәйкес таңдалады. Отандық психологтар сенімді интим әңгімесі, фантазияны іске асырудың құралы деп өмірдегі байланыстарға теріс әсер ету.